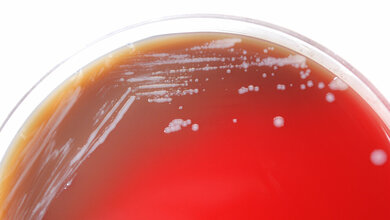
Burkholderia mallei

Forscher des Leibniz-Instituts für Naturstoff-Forschung und Infektionsbiologie – Hans-Knöll-Institut (Leibniz-HKI) in Jena haben ein Enzym als neuen Ansatzpunkt gegen die gefährliche bakterielle Infektion Melioidose identifiziert. Das pathogene Bakterium Burkholderia pseudomallei nutzt es zum Bau einer molekularen Struktur, die eine entscheidende Rolle bei der Infektion spielt. „Ohne Behandlung verläuft die Krankheit meist tödlich“, erklärt Christian Hertweck, Leiter der Abteilung Biomolekulare Chemie am Leibniz-HKI und Professor für Naturstoffchemie an der Friedrich-Schiller-Universität Jena. „Und selbst eine Antibiotikabehandlung zieht sich häufig über viele Monate und ist nicht immer erfolgreich, weil gängige Medikamente gegen diese Erreger nicht gut wirken.“
Möglicher neuer Ansatzpunkt zur Bekämpfung
Die Forschungsgruppe möchte deswegen die Infektionsmechanismen des Bakteriums besser verstehen und ist dabei auf einen möglichen neuen Ansatzpunkt zur Bekämpfung der Erkrankung gestoßen. „Wir haben ein Enzym gefunden, das eine für die Infektion zentrale molekulare Struktur synthetisiert“, erklärt Felix Trottmann, Erstautor der Studie. Das Enzym (BurG) bildet aus einem Vorläufer-Molekül einen Cyclopropanol-Ring, eine hoch reaktive chemische Verbindung. In vorherigen Studien konnte Trottmann bereits zeigen, dass diese Struktur von mehreren pathogenen Bakterien aus der Gattung Burkholderia gebildet wird und offenbar eine wichtige Rolle bei der Infektion spielt. Werde der Biosyntheseweg für dieses Molekül durch Mutationen ausgeschaltet, seien die Bakterien weit weniger gefährlich, so die Wissenschaftler.
Wirkstoffe designen?
Das Forschungsteam hat außerdem in Kooperation mit Michael Groll von der TU München die 3-D-Struktur des Enzyms aufgeklärt. „In einem nächsten Schritt können wir jetzt versuchen, Wirkstoffe zu designen, die das Enzym inhibieren und die Bakterien so weniger virulent machen“, erläutert Trottmann. Das Enzym komme, soweit bekannt, nur in Bakterien vor und nicht im Menschen. „Die Hoffnung ist deshalb, die Bakterien spezifisch hemmen zu können“, so Hertweck. Das Immunsystem könnte dann leichter mit ihnen fertig werden.
Experimente mit Burkholderia thailandensis
Um die Biosynthese der für die Infektion zentralen molekularen Struktur zu verstehen, hatten sich die Forscher das Gencluster angeschaut, das die dafür notwendigen DNA-Informationen enthält. Die Laborexperimente führten sie mit Burkholderia thailandensis durch, die Burkholderia pseudomallei zwar sehr ähnlich, aber wesentlich harmloser sind. Melioidose tritt bisher hauptsächlich in Südostasien und Australien auf. Experten warnen aber, dass sich die Krankheit weiter ausbreiten könnte. So konnten etwa die US Centers for Disease Control and Prevention (CDC) die Ursache für vier Melioidose-Fälle im vergangenen Jahr, von denen zwei tödlich ausgingen, auf ein Aromaspray zurückführen. Eine nah verwandte Art, B. mallei, die ebenfalls den Cyclopropanol-Ring bildet, wurde zudem als biologische Waffe im Ersten und Zweiten Weltkrieg eingesetzt. Und auch B. pseudomallei wurde in einigen Ländern als solche erforscht.
Quelle: idw/Leibniz-HKI
Artikel teilen